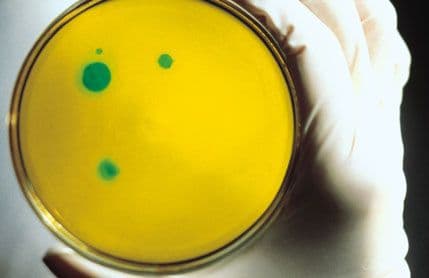
Kad antibiotici ne ubijaju bakterije... Kad antibiotici ne ubijaju bakterije...

U nekoliko posljednjih decenija je, inače, lansirano samo nekoliko vrsta ljekova iz ove grupe, dok su istovremeno infekcije tzv. "superbakterijama" sve učestalije.
Jedna od najpoznatijih superbakterija MRSA u SAD godišnje usmrti oko 19.000 osoba - znatno više nego sida. Otprilike isto toliko ljudi strada od ove bakterije i u EU.
Posljednjih godina su se pojavili i slučajevi na sve antibiotike otporne tuberkuloze i gonoreje, kao i novi talas "super super bakterija", od kojih je najpoznatija NDM1, koja je prije neku godinu prvi put utvrđena u Indiji, a danas se može naći od Britanije do Novog Zelanda.
Stručnjaci ističu da je nužno pojačano praćenje i nadzor nad superbakterijama, selektivnije prepisivanje antibiotika, samo onda kad je to zaista nužno, kao i poboljšana higijena, naročito u zdravstvenim ustanovama, kako bi se infekcije svele na minimum.
Najdžel Braun
, predsjednik britanskog Društva za opštu mikrobiologiju, napominje da će mikrobiološke tehnike i nova dostignuća u oblasti sintetičke biologije biti od ključne važnosti u borbi protiv superbakterija.
tekst i foto: mondo.rs